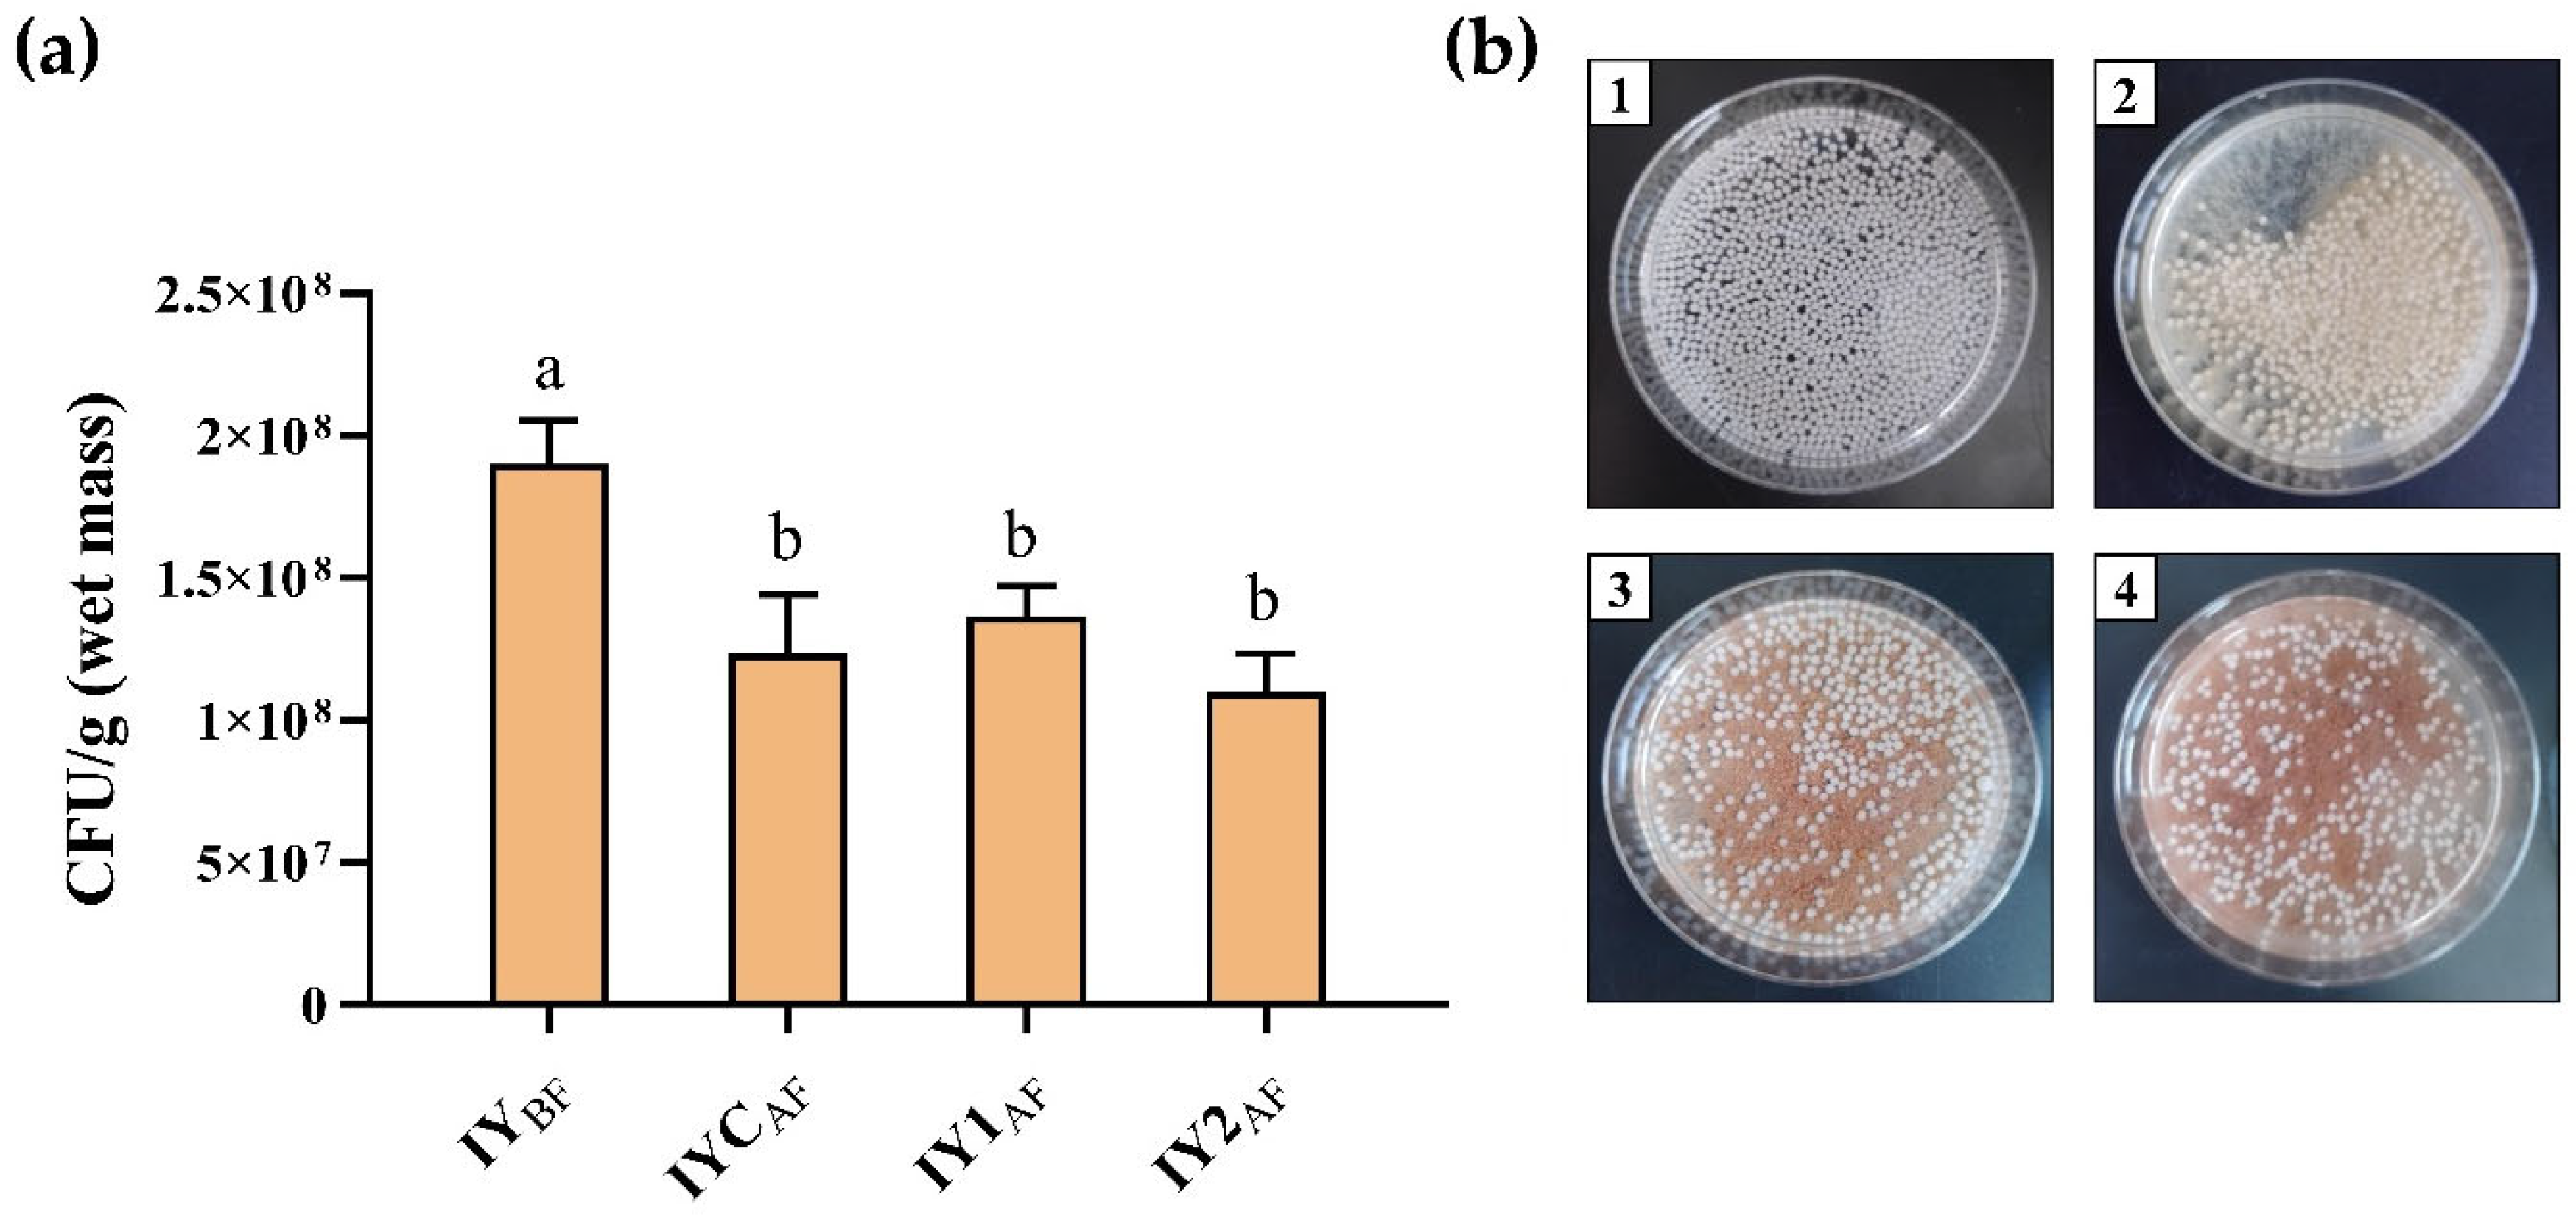
Foods 13 02801 g005

Craft Beer Produced by Immobilized Yeast Cells with the Addition of Grape Pomace Seed Powder: Physico-Chemical Characterization and Antioxidant Properties
Abstract
1. Introduction
2. Material and Methods
2.1. Materials
2.2. Preparation of Grape Pomace Seed Powder
2.3. Immobilization of Yeast Cells
Morphological Properties and Microstructure of Immobilized Yeast Cells
2.4. Brewing Technology
2.4.1. Kinetics of Fermentation and Color Measurements
2.4.2. UHPLC Q-ToF MS Analysis of Bioactive Compounds
2.4.3. Total Phenolic Content and Antioxidant Properties
2.4.4. Cell Viability before and after Fermentation
2.4.5. Sensory Evaluation of the Craft Beers
2.5. Statistical Analysis
3. Results and Discussion
3.1. Morphological Properties of the Ca-Alginate Beads with Immobilized Yeast Cells
3.2. Fermentation Kinetics and Color Measurements
3.3. UHPLC/Q-ToF/MS Analysis of Phenolic Compounds
3.4. UHPLC Q-ToF MS Analysis of Hop-Derived Bitter Acids
3.5. Total Phenolic Content and Antioxidant Properties
3.6. Yeast Cell Viability after Fermentation
3.7. Sensory Properties of the Produced Craft Beers
4. Conclusions
Supplementary Materials
Author Contributions
Funding
Institutional Review Board Statement
Informed Consent Statement
Data Availability Statement
Conflicts of Interest
References
- Tirado-Kulieva, V.A.; Hernández-Martínez, E.; Minchán-Velayarce, H.H.; Pasapera-Campos, S.E.; Luque-Vilca, O.M. A comprehensive review of the benefits of drinking craft beer: Role of phenolic content in health and possible potential of the alcoholic fraction. Curr. Res. Food Sci. 2023, 6, 100477. [Google Scholar] [CrossRef]
- Paiva, R.A.M.; Mutz, Y.S.; Conte-Junior, C.A. A Review on the Obtaining of Functional Beers by Addition of Non-Cereal Adjuncts Rich in Antioxidant Compounds. Antioxidants 2021, 10, 1332. [Google Scholar] [CrossRef] [PubMed]
- Breda, C.; Barros, A.I.; Gouvinhas, I. Characterization of bioactive compounds and antioxidant capacity of Portuguese craft beers. Int. J. Gastron. Food Sci. 2022, 27, 100473. [Google Scholar] [CrossRef]
- Lerro, M.; Marotta, G.; Nazzaro, C. Measuring consumers’ preferences for craft beer attributes through Best-Worst Scaling. Agric. Food Econ. 2020, 8, 1. [Google Scholar] [CrossRef]
- Gasiński, A.; Kawa-Rygielska, J.; Mikulski, D.; Kłosowski, G.; Głowacki, A. Application of white grape pomace in the brewing technology and its impact on the concentration of esters and alcohols, physicochemical parameteres and antioxidative properties of the beer. Food Chem. 2022, 367, 130646. [Google Scholar] [CrossRef]
- Salanță, L.C.; Coldea, T.E.; Ignat, M.V.; Pop, C.R.; Tofană, M.; Mudura, E.; Borșa, A.; Pasqualone, A.; Zhao, H. Non-Alcoholic and Craft Beer Production and Challenges. Processes 2020, 8, 1382. [Google Scholar] [CrossRef]
- Pallottino, F.; Cimini, A.; Costa, C.; Antonucci, F.; Menesatti, P.; Moresi, M. Bibliometric analysis and mapping of publications on brewing science from 1940 to 2018. J. Inst. Brew. 2020, 126, 394–405. [Google Scholar] [CrossRef]
- Mellor, D.D.; Hanna-Khalil, B.; Carson, R. A Review of the Potential Health Benefits of Low Alcohol and Alcohol-Free Beer: Effects of Ingredients and Craft Brewing Processes on Potentially Bioactive Metabolites. Beverages 2020, 6, 25. [Google Scholar] [CrossRef]
- Styburski, D.; Janda, K.; Baranowska-Bosiacka, I.; Łukomska, A.; Dec, K.; Goschorska, M.; Michalkiewicz, B.; Ziętek, P.; Gutowska, I. Beer as a potential source of macroelements in a diet: The analysis of calcium, chlorine, potassium, and phosphorus content in a popular low-alcoholic drink. Eur. Food Res. Technol. 2018, 244, 1853–1860. [Google Scholar] [CrossRef]
- Sohrabvandi, S.; Mortazavian, A.; Rezaei, K. Health-related aspects of beer: A review. Int. J. Food Prop. 2012, 15, 350–373. [Google Scholar] [CrossRef]
- Habschied, K.; Živković, A.; Krstanović, V.; Mastanjević, K. Functional Beer—A Review on Possibilities. Beverages 2020, 6, 51. [Google Scholar] [CrossRef]
- Pluháčková, H.; Gregor, T.; Boško, R.; Běláková, S.; Svoboda, Z.; Benešová, K. Fortification of Beer with Extracts of the Selected Czech Medicinal Herbs and Plants. Kvasny Prumysl 2020, 66, 314–319. [Google Scholar] [CrossRef]
- Piva, R.C.; Verdan, M.H.; Mascarenhas Santos, M.D.S.; Batistote, M.; Cardoso, C.A.L. Manufacturing and characterization of craft beers with leaves from Ocimum selloi Benth. J. Food Sci. Technol. 2021, 58, 4403–4410. [Google Scholar] [CrossRef] [PubMed]
- Djordjević, S.; Popović, D.; Despotović, S.; Veljović, M.; Atanacković, M.; Cvejić, J.; Nedović, V.; Leskošek-Čukalović, I. Extracts of medicinal plants as functional beer additives. Chem. Ind. Chem. Eng. Q. CICEQ 2016, 22, 301–308. [Google Scholar] [CrossRef]
- Dziedziński, M.; Stachowiak, B.; Kobus-Cisowska, J.; Kozłowski, R.; Stuper-Szablewska, K.; Szambelan, K.; Górna, B. Supplementation of beer with Pinus sylvestris L. shoots extracts and its effect on fermentation, phenolic content, antioxidant activity and sensory profiles. Electron. J. Biotechnol. 2023, 63, 10–17. [Google Scholar] [CrossRef]
- Borșa, A.; Muntean, M.V.; Salanță, L.C.; Tofană, M.; Socaci, S.A.; Mudura, E.; Pop, A.; Pop, C.R. Effects of Botanical Ingredients Addition on the Bioactive Compounds and Quality of Non-Alcoholic and Craft Beer. Plants 2022, 11, 1958. [Google Scholar] [CrossRef] [PubMed]
- Sánchez-Bravo, P.; Abellán, Á.; Zapata, P.J.; García-Viguera, C.; Domínguez-Perles, R.; Giménez, M.J. Broccoli products supplemented beers provide a sustainable source of dietary sulforaphane. Food Biosci. 2023, 51, 102259. [Google Scholar] [CrossRef]
- Zapata, P.J.; Martínez-Esplá, A.; Gironés-Vilaplana, A.; Santos-Lax, D.; Noguera-Artiaga, L.; Carbonell-Barrachina, Á.A. Phenolic, volatile, and sensory profiles of beer enriched by macerating quince fruits. LWT 2019, 103, 139–146. [Google Scholar] [CrossRef]
- Nardini, M.; Garaguso, I. Characterization of bioactive compounds and antioxidant activity of fruit beers. Food Chem. 2020, 305, 125437. [Google Scholar] [CrossRef]
- Yang, N.; Wu, C.; Yang, H.; Guo, Z.; Jian, H.; Jiang, T.; Lei, H. Bioactive compounds, antioxidant activities and flavor volatiles of lager beer produced by supplementing six jujube cultivars as adjuncts. Food Biosci. 2022, 50, 102008. [Google Scholar] [CrossRef]
- Ducruet, J.; Rébénaque, P.; Diserens, S.; Kosińska-Cagnazzo, A.; Héritier, I.; Andlauer, W. Amber ale beer enriched with goji berries—The effect on bioactive compound content and sensorial properties. Food Chem. 2017, 226, 109–118. [Google Scholar] [CrossRef] [PubMed]
- Belscak-Cvitanović, A.; Nedović, V.; Salević, A.; Despotović, S.; Komes, D.; Nikšić, M.; Bugarski, B.; Leskošek-Čukalović, I. Modification of functional quality of beer by using microencapsulated green tea (Camellia sinensis L.) and ganoderma mushroom (Ganoderma lucidum L.) bioactive compounds. Chem. Ind. Chem. Eng. Q. 2017, 23, 457–471. [Google Scholar] [CrossRef]
- Ulloa, P.; Vidal, J.; Ávila, M.; Labbe, M.; Cohen, S.; Salazar, F. Effect of the Addition of Propolis Extract on Bioactive Compounds and Antioxidant Activity of Craft Beer. J. Chem. 2017, 2017, 6716053. [Google Scholar] [CrossRef]
- Ky, I.; Lorrain, B.; Kolbas, N.; Crozier, A.; Teissedre, P.-L. Wine by-products: Phenolic characterization and antioxidant activity evaluation of grapes and grape pomaces from six different French grape varieties. Molecules 2014, 19, 482–506. [Google Scholar] [CrossRef]
- Beres, C.; Costa, G.N.S.; Cabezudo, I.; da Silva-James, N.K.; Teles, A.S.C.; Cruz, A.P.G.; Mellinger-Silva, C.; Tonon, R.V.; Cabral, L.M.C.; Freitas, S.P. Towards integral utilization of grape pomace from winemaking process: A review. Waste Manag. 2017, 68, 581–594. [Google Scholar] [CrossRef]
- Pasini Deolindo, C.T.; Monteiro, P.I.; Santos, J.S.; Cruz, A.G.; Cristina da Silva, M.; Granato, D. Phenolic-rich Petit Suisse cheese manufactured with organic Bordeaux grape juice, skin, and seed extract: Technological, sensory, and functional properties. LWT 2019, 115, 108493. [Google Scholar] [CrossRef]
- Chouchouli, V.; Kalogeropoulos, N.; Konteles, S.J.; Karvela, E.; Makris, D.P.; Karathanos, V.T. Fortification of yoghurts with grape (Vitis vinifera) seed extracts. LWT—Food Sci. Technol. 2013, 53, 522–529. [Google Scholar] [CrossRef]
- Sagdic, O.; Ozturk, I.; Cankurt, H.; Tornuk, F. Interaction Between Some Phenolic Compounds and Probiotic Bacterium in Functional Ice Cream Production. Food Bioprocess Technol. 2012, 5, 2964–2971. [Google Scholar] [CrossRef]
- Ribas-Agustí, A.; Gratacós-Cubarsí, M.; Sárraga, C.; Guàrdia, M.D.; García-Regueiro, J.-A.; Castellari, M. Stability of phenolic compounds in dry fermented sausages added with cocoa and grape seed extracts. LWT—Food Sci. Technol. 2014, 57, 329–336. [Google Scholar] [CrossRef]
- Milinčić, D.D.; Kostić, A.Ž.; Kolašinac, S.; Rac, V.; Banjac, N.; Lađarević, J.; Lević, S.; Pavlović, V.B.; Stanojević, S.P.; Nedović, V.A.; et al. Goat milk powders enriched with grape pomace seed extract: Physical and techno-functional properties. Food Hydrocoll. 2023, 146, 109293. [Google Scholar] [CrossRef]
- García-Lomillo, J.; González-SanJosé, M.L. Applications of Wine Pomace in the Food Industry: Approaches and Functions. Compr. Rev. Food Sci. Food Saf. 2017, 16, 3–22. [Google Scholar] [CrossRef] [PubMed]
- Pešić, M.B.; Milinčić, D.D.; Kostić, A.Ž.; Stanisavljević, N.S.; Vukotić, G.N.; Kojić, M.O.; Gašić, U.M.; Barać, M.B.; Stanojević, S.P.; Popović, D.A.; et al. In vitro digestion of meat- and cereal-based food matrix enriched with grape extracts: How are polyphenol composition, bioaccessibility and antioxidant activity affected? Food Chem. 2019, 284, 28–44. [Google Scholar] [CrossRef]
- Milinčić, D.D.; Stanisavljević, N.S.; Kostić, A.Ž.; Soković Bajić, S.; Kojić, M.O.; Gašić, U.M.; Barać, M.B.; Stanojević, S.P.; Lj Tešić, Ž.; Pešić, M.B. Phenolic compounds and biopotential of grape pomace extracts from Prokupac red grape variety. LWT 2021, 138, 110739. [Google Scholar] [CrossRef]
- Godjevac, D.; Tesevic, V.; Velickovic, M.; Vujisic, L.; Vajs, V.; Milosavljevic, S. Polyphenolic compounds in seeds from some grape cultivars grown in Serbia. J. Serb. Chem. Soc. 2010, 75, 1641–1652. [Google Scholar] [CrossRef]
- Zdunić, G.; Gođevac, D.; Šavikin, K.; Krivokuća, D.; Mihailović, M.; Pržić, Z.; Marković, N. Grape Seed Polyphenols and Fatty Acids of Autochthonous Prokupac Vine Variety from Serbia. Chem. Biodivers. 2019, 16, e1900053. [Google Scholar] [CrossRef]
- Bolanos-Barbosa, A.D.; Rodríguez, C.F.; Acuña, O.L.; Cruz, J.C.; Reyes, L.H. The Impact of Yeast Encapsulation in Wort Fermentation and Beer Flavor Profile. Polymers 2023, 15, 1742. [Google Scholar] [CrossRef]
- Nedović, V.; Gibson, B.; Mantzouridou, T.F.; Bugarski, B.; Djordjević, V.; Kalušević, A.; Paraskevopoulou, A.; Sandell, M.; Šmogrovičová, D.; Yilmaztekin, M. Aroma formation by immobilized yeast cells in fermentation processes. Yeast 2015, 32, 173–216. [Google Scholar] [CrossRef]
- Verbelen, P.J.; Nedović, V.A.; Manojlović, V.; Delvaux, F.R.; Laskošek-Čukalović, I.; Bugarski, B.; Willaert, R. Bioprocess Intensification of Beer Fermentation Using Immobilised Cells. In Encapsulation Technologies for Active Food Ingredients and Food Processing; Zuidam, N.J., Nedovic, V., Eds.; Springer: New York, NY, USA, 2010; pp. 303–325. [Google Scholar] [CrossRef]
- Nedovic, V.; Kalusevic, A.; Manojlovic, V.; Levic, S.; Bugarski, B. An overview of encapsulation technologies for food applications. Procedia Food Sci. 2011, 1, 1806–1815. [Google Scholar] [CrossRef]
- Milinčić, D.; Kostić, A.; Špirović-Trifunović, B.; Tesic, Z.; Tosti, T.; Dramićanin, A.; Barac, M.; Pešić, M. Grape seed flour of different grape pomaces: Fatty acid profile, soluble sugar profile and nutritional value. J. Serb. Chem. Soc. 2020, 85, 305–319. [Google Scholar] [CrossRef]
- Ferreira, I.M.; Carvalho, D.O.; da Silva, M.G.; Guido, L.F. Gas-Diffusion Microextraction (GDME) Combined with Derivatization for Assessing Beer Staling Aldehydes: Validation and Application. Foods 2021, 10, 1704. [Google Scholar] [CrossRef]
- Milinčić, D.D.; Vidović, B.B.; Gašić, U.M.; Milenković, M.; Kostić, A.Ž.; Stanojević, S.P.; Ilić, T.; Pešić, M.B. A systematic UHPLC Q-ToF MS approach for the characterization of bioactive compounds from freeze-dried red goji berries (L. barbarum L.) grown in Serbia: Phenolic compounds and phenylamides. Food Chem. 2024, 456, 140044. [Google Scholar] [CrossRef]
- Andrés-Iglesias, C.; Blanco, C.A.; Blanco, J.; Montero, O. Mass spectrometry-based metabolomics approach to determine differential metabolites between regular and non-alcohol beers. Food Chem. 2014, 157, 205–212. [Google Scholar] [CrossRef] [PubMed]
- Cvijetić, I.; Bigović, M.; Ristivojević, P.; Vitorović-Todorović, M.; Zloh, M.; Milojković-Opsenica, D. DFT study of the radical scavenging activity of isoxanthohumol, humulones (α-acids), and iso-α-acids from beer. Struct. Chem. 2021, 32, 2051–2059. [Google Scholar] [CrossRef]
- Dušek, M.; Olšovská, J.; Krofta, K.; Jurková, M.; Mikyška, A. Qualitative Determination of β-Acids and Their Transformation Products in Beer and Hop Using HR/AM-LC-MS/MS. J. Agric. Food Chem. 2014, 62, 7690–7697. [Google Scholar] [CrossRef]
- Quifer-Rada, P.; Vallverdú-Queralt, A.; Martínez-Huélamo, M.; Chiva-Blanch, G.; Jáuregui, O.; Estruch, R.; Lamuela-Raventós, R. A comprehensive characterisation of beer polyphenols by high resolution mass spectrometry (LC-ESI-LTQ-Orbitrap-MS). Food Chem. 2015, 169, 336–343. [Google Scholar] [CrossRef] [PubMed]
- Ristivojević, P.M.; Morlock, G.E. Effect-directed classification of biological, biochemical and chemical profiles of 50 German beers. Food Chem. 2018, 260, 344–353. [Google Scholar] [CrossRef]
- Wang, L.; Hong, K.; Agbaka, J.I.; Zhu, G.; Lv, C.; Ma, C. Application of UHPLC-Q/TOF-MS-based metabolomics analysis for the evaluation of bitter-tasting Krausen metabolites during beer fermentation. J. Food Compos. Anal. 2021, 99, 103850. [Google Scholar] [CrossRef]
- Dresel, M.; Dunkel, A.; Hofmann, T. Sensomics Analysis of Key Bitter Compounds in the Hard Resin of Hops (Humulus lupulus L.) and Their Contribution to the Bitter Profile of Pilsner-Type Beer. J. Agric. Food Chem. 2015, 63, 3402–3418. [Google Scholar] [CrossRef]
- Milinčić, D.D.; Kostić, A.Ž.; Gašić, U.M.; Lević, S.; Stanojević, S.P.; Barać, M.B.; Tešić, Ž.L.; Nedović, V.; Pešić, M.B. Skimmed Goat’s Milk Powder Enriched with Grape Pomace Seed Extract: Phenolics and Protein Characterization and Antioxidant Properties. Biomolecules 2021, 11, 965. [Google Scholar] [CrossRef]
- Souza, A.C.; Simões, L.; Schwan, R.; Dias, D. Enumerating Yeast in Foods and Water Using the Spread Plating Technique. In Detection and Enumeration of Bacteria, Yeast, Viruses, and Protozoan in Foods and Freshwater; Magnani, M., Ed.; Methods and Protocols in Food Science; Humana: New York, NY, USA, 2021; pp. 93–110. [Google Scholar] [CrossRef]
- ISO 8586:2023; Sensory Analysis—Selection and Training of Sensory Assessors. ISO: Geneva, Switzerland, 2023.
- Senate of the University of Belgrade. The Code of Professional Ethics of the University of Belgrade. Off. Gaz. Repub. Serb. 2016, 189/16, 16. [Google Scholar]
- MEBAK. Sensory Analysis. Available online: https://www.carllibri.com/epages/62355332.sf/en_GB/?ObjectID=38260772 (accessed on 23 July 2023).
- Pajic-Lijakovic, I.; Levic, S.; Hadnađev, M.; Stevanovic-Dajic, Z.; Radosevic, R.; Nedovic, V.; Bugarski, B. Structural changes of Ca-alginate beads caused by immobilized yeast cell growth. Biochem. Eng. J. 2015, 103, 32–38. [Google Scholar] [CrossRef]
- Bugarski, B.; Li, Q.; Goosen, M.; Poncelet, D.; Neufeld, R.; Vunjak-Novakovic, G. Electrostatic Droplet Generation: Mechanism of Polymer Droplet Formation. AIChE J. 1994, 40, 1026–1031. [Google Scholar] [CrossRef]
- Kim, D.H.; Lee, S.B.; Park, H.D. Effect of air-blast drying and the presence of protectants on the viability of yeast entrapped in calcium alginate beads with an aim to improve the survival rate. Appl. Microbiol. Biotechnol. 2017, 101, 93–102. [Google Scholar] [CrossRef] [PubMed]
- Carvalho, G.B.; Silva, D.P.; Bento, C.V.; Vicente, A.A.; Teixeira, J.A.; Felipe, M.; Almeida, E.S.J.B. Banana as adjunct in beer production: Applicability and performance of fermentative parameters. Appl. Biochem. Biotechnol. 2009, 155, 356–365. [Google Scholar] [CrossRef]
- Koren, D.; Vecseri, B.; Kun-Farkas, G.; Urbin, Á.; Nyitrai, Á.; Sipos, L. How to objectively determine the color of beer? J. Food Sci. Technol. 2020, 57, 1183–1189. [Google Scholar] [CrossRef]
- Zhao, H.; Chen, W.; Lu, J.; Zhao, M. Phenolic profiles and antioxidant activities of commercial beers. Food Chem. 2010, 119, 1150–1158. [Google Scholar] [CrossRef]
- Ma, W.; Waffo-Teguo, P.; Jourdes, M.; Li, H.; Teissedre, P.L. Chemical Affinity between Tannin Size and Salivary Protein Binding Abilities: Implications for Wine Astringency. PLoS ONE 2016, 11, e0161095. [Google Scholar] [CrossRef]
- Intelmann, D.; Haseleu, G.; Hofmann, T. LC-MS/MS Quantitation of Hop-Derived Bitter Compounds in Beer Using the ECHO Technique. J. Agric. Food Chem. 2009, 57, 1172–1182. [Google Scholar] [CrossRef]
- Vanhoenacker, G.; De Keukeleire, D.; Sandra, P. Analysis of iso-α-acids and reduced iso-α-acids in beer by direct injection and liquid chromatography with ultraviolet absorbance detection or with mass spectrometry. J. Chromatogr. A 2004, 1035, 53–61. [Google Scholar] [CrossRef]
- Farag, M.A.; Porzel, A.; Schmidt, J.; Wessjohann, L.A. Metabolite profiling and fingerprinting of commercial cultivars of Humulus lupulus L. (hop): A comparison of MS and NMR methods in metabolomics. Metabolomics 2012, 8, 492–507. [Google Scholar] [CrossRef]
- Zhang, X.; Liang, X.; Xiao, H.; Xu, Q. Direct characterization of bitter acids in a crude hop extract by liquid chromatography-atmospheric pressure chemical ionization mass spectrometry. J. Am. Soc. Mass Spectrom. 2004, 15, 180–187. [Google Scholar] [CrossRef] [PubMed]
- Serea, D.; Horincar, G.; Constantin, O.E.; Aprodu, I.; Stănciuc, N.; Bahrim, G.E.; Stanciu, S.; Rapeanu, G. Value-Added White Beer: Influence of Red Grape Skin Extract on the Chemical Composition, Sensory and Antioxidant Properties. Sustainability 2022, 14, 9040. [Google Scholar] [CrossRef]
- Deng, Y.; Lim, J.; Nguyen, T.T.H.; Mok, I.K.; Piao, M.; Kim, D. Composition and biochemical properties of ale beer enriched with lignans from Schisandra chinensis Baillon (omija) fruits. Food Sci. Biotechnol. 2020, 29, 609–617. [Google Scholar] [CrossRef] [PubMed]
- Nedović, V.A.; Obradović, B.; Leskošek-Čukalović, I.; Trifunović, O.; Pešić, R.; Bugarski, B. Electrostatic generation of alginate microbeads loaded with brewing yeast. Process Biochem. 2001, 37, 17–22. [Google Scholar] [CrossRef]
- Padilla-González, G.F.; Grosskopf, E.; Sadgrove, N.J.; Simmonds, M.S.J. Chemical Diversity of Flavan-3-Ols in Grape Seeds: Modulating Factors and Quality Requirements. Plants 2022, 11, 809. [Google Scholar] [CrossRef]
- Cadenas, R.; Caballero, I.; Nimubona, D.; Blanco, C.A. Brewing with Starchy Adjuncts: Its Influence on the Sensory and Nutritional Properties of Beer. Foods 2021, 10, 1726. [Google Scholar] [CrossRef]

| RT | Compound Name | Formula | Calculated Mass | m/z Exact Mass | mDa | MS Fragments (%) | CBC (0%GS) | CB1 (2.5%GS) | CB2 (5.0% GS) |
|---|---|---|---|---|---|---|---|---|---|
| Phenolic acid and derivatives | µg/100 mL | ||||||||
| 5.45 | Hydroxybenzoic acid b | C7H5O3− | 137.02442 | 137.02178 | 2.64 | 107.01056 (2), 108.01857 (100), 109.02364 (13) | <LOQ | <LOQ | <LOQ |
| 3.36 | Dihydroxybenzoic acid (gentisic acid) a | C7H5O4− | 153.01880 | 153.01664 | 2.16 | 108.01898 (100), 109.02631 (79) | <LOQ | 92.23 | 106.65 |
| 1.55 | Gallic acid a | C7H5O5− | 169.01370 | 169.01118 | 2.52 | 123.00633 (13), 124.01324 (77), 125.0212 (100), 126.02303 (5) | <LOQ | <LOQ | <LOQ |
| 6.87 | Caffeic acid a | C9H7O4− | 179.03440 | 179.03355 | 0.85 | 134.03343 (68), 135.04142 (100), 136.04448 (7) | <LOQ | <LOQ | <LOQ |
| 7.71 | Ethyl gallate b | C9H9O5− | 197.04500 | 197.04182 | 3.18 | 124.01366 (100), 125.02059 (26), 169.01088 (2) | - | 36.58 | 47.74 |
| 4.24 | Galloylglycerol b | C10H11O7− | 243.05103 | 243.04792 | 3.11 | 124.01305 (100), 125.01936 (26), 168.00139 (1), 169.01007 (7) | - | <LOQ | <LOQ |
| 8.15 | Ellagic acid a | C14H5O8− | 300.99840 | 300.99661 | 1.79 | 145.02634 (9), 173.02153 (9), 185.02169 (11), 201.01519 (13), 229.01071 (20), 245.00621 (10), 257.00635 (8), 283.99209 (19), 299.9868 (19), 300.99392 (100) | - | 450.30 | 604.76 |
| 5.32 | Vanilloloside b | C14H19O8− | 315.10800 | 315.10305 | 4.95 | 109.02781 (2), 123.04196 (100), 124.04444 (10), 153.05208 (57) | <LOQ | <LOQ | <LOQ |
| 5.78 | Caffeoylquinic acid is. I a | C16H17O9− | 353.08730 | 353.08623 | 1.07 | 134.03304 (5), 135.04205 (90), 136.04463 (11), 161.02029 (5), 173.0435 (3), 178.06898 (8), 179.03108 (40), 191.05243 (100) | 20.28 | 18.93 | - |
| 6.87 | Caffeoylquinic acid is. II a | C16H17O9− | 353.08730 | 353.08920 | −1.90 | 109.03236 (35), 111.04331 (38), 127.04667 (35), 135.0412 (100), 173.04221 (69), 179.03145 (49), 181.05164 (32), 191.05235 (67) | <LOQ | <LOQ | <LOQ |
| 4.78 | Digalloyl hexoside is. I b | C20H19O14− | 483.07750 | 483.07412 | 3.38 | 125.0209 (23), 169.01034 (100), 313.05237 (15), 331.06114 (17), 483.07152 (4) | - | <LOQ | <LOQ |
| 5.99 | Digalloyl hexoside is. II b | C20H19O14− | 483.07750 | 483.07603 | 1.47 | 124.01285 (13), 125.02154 (17), 168.00296 (7), 169.00982 (100), 170.01459 (8), 313.0512 (46), 331.06191 (18), 483.07265 (22) | - | <LOQ | <LOQ |
| ∑ | 20.28 | 598.04 | 759.15 | ||||||
| Flavan-3-ols and derivatives (carriers of astringency) | |||||||||
| 6.67 | Catechin a | C15H13O6− | 289.07120 | 289.06851 | 2.69 | 109.02686 (95), 123.04219 (100), 125.02149 (43), 137.02151 (24), 151.0369 (31), 161.05632 (13), 187.03687 (10), 203.06718 (19), 221.07814 (12) | 448.56 | 2110.50 | 2776.98 |
| 7.27 | Epicatechin a | C15H13O6− | 289.07120 | 289.06898 | 2.22 | 109.02615 (93), 121.02596 (27), 123.04157 (100), 125.02079 (41), 137.02084 (27), 151.03622 (31), 161.05521 (13), 203.06606 (18), 247.01958 (36) | 91.63 | 817.92 | 954.21 |
| 4.31 | Gallocatechin a | C15H13O7− | 305.06610 | 305.06197 | 4.13 | 109.02535 (17), 111.04193 (20), 124.01198 (15), 125.02097 (100), 137.02086 (34), 139.03679 (36), 165.01568 (14), 167.03209 (28), 219.06303 (7) | 262.64 | 434.56 | 436.78 |
| 6.80 | Epigallocatechin a | C15H13O7− | 305.06610 | 305.06540 | 0.70 | 109.02586 (78), 121.02668 (40), 125.02004 (100), 137.02051 (74), 161.01937 (63), 165.0125 (24), 177.05024 (20), 219.04178 (17) | - | 29.94 | 44.88 |
| 8.22 | Epicatechin gallate a | C22H17O10− | 441.08220 | 441.08035 | 1.85 | 124.01275 (12), 125.021 (50), 169.01013 (100), 203.06594 (7), 245.07733 (14), 289.0667 (22), 290.07051 (4) | - | 28.58 | 38.55 |
| 5.66 | Epicatechin-hexoside c | C21H23O11− | 451.12400 | 451.12297 | 1.03 | 109.02619 (13), 125.02073 (16), 137.01963 (19), 165.01606 (12), 179.03194 (13), 203.06608 (19), 245.07746 (46), 289.06674 (100), 290.0686 (22) | - | 70.54 | 85.82 |
| 6.67 | Chalcan-flavan-3-ol dimer is. I c | C30H27O12− | 579.15030 | 579.14317 | 7.13 | 125.02129 (8), 137.02117 (7), 165.01593 (4), 179.0316 (8), 203.06795 (8), 205.04707 (9), 245.07829 (32), 289.06755 (100), 290.07123 (18) | <LOQ | 457.61 | 688.91 |
| 7.27 | Chalcan-flavan-3-ol dimer is. II c | C30H27O12− | 579.15030 | 579.14289 | 7.41 | 109.02562 (6), 123.04177 (3), 125.02111 (9), 137.02051 (7), 179.03031 (9), 203.06649 (9), 205.0457 (10), 245.07724 (32), 289.0667 (100), 290.06995 (19) | - | 423.80 | 628.89 |
| ∑ | 802.83 | 4373.44 | 5655.03 | ||||||
| Pro (antho)cyanidins and derivatives (carriers of astringency) | |||||||||
| 6.45 | Procyanidin dimer B type is. I d | C30H25O12− | 577.13460 | 577.13297 | 1.63 | 109.02687 (5), 125.0212 (8), 137.02169 (6), 179.03134 (8), 203.06758 (8), 205.04685 (8), 245.07818 (32), 289.06792 (100), 290.07144 (11) | 31.54 | 157.70 | 286.08 |
| 7.07 | Procyanidin dimer B type is. II d | C30H25O12− | 577.13460 | 577.13164 | 2.96 | 125.0209 (78), 137.02014 (11), 161.02007 (23), 205.04439 (7), 245.07585 (20), 289.06625 (100), 290.07029 (19), 339.08218 (10), 407.07089 (80), 425.08362 (7) | - | 65.40 | 104.22 |
| 4.24 | B type prodelphinidin dimer is. I d | C30H25O13− | 593.12959 | 593.12439 | 5.20 | 125.02157 (69), 177.01565 (80), 245.07743 (16), 273.03602 (10), 289.06714 (85), 339.08109 (12), 407.07203 (100), 425.07974 (10) | 48.17 | 157.15 | 171.39 |
| 5.39 | B type prodelphinidin dimer is. II d | C30H25O13− | 593.12959 | 593.12633 | 3.26 | 125.02103 (73), 177.01556 (76), 245.07834 (18), 273.03567 (10), 289.06740 (84), 339.08302 (14), 407.07303 (100), 425.08266 (11) | 52.44 | 103.98 | 113.24 |
| 7.68 | B type procyanidin dimer gallate d | C37H29O16− | 729.14566 | 729.14313 | 2.53 | 125.02093 (37), 169.01008 (21), 271.05517 (14), 289.0666 (80), 290.07017 (13), 407.07168 (100), 408.07294 (28), 441.07322 (10), 451.09645 (21), 577.12136 (13) | - | 44.73 | 79.36 |
| 6.53 | B type procyanidin trimer is. I e | C45H37O18− | 865.19802 | 865.19536 | 2.66 | 125.01991 (96), 243.0246 (29), 287.05074 (100), 289.06765 (57), 407.07436 (66), 425.08143 (59), 451.09605 (29), 575.11216 (55), 577.12083 (64), 865.18724 (48) | - | 125.44 | 220.22 |
| 6.87 | B type procyanidin trimer is. II e | C45H37O18− | 865.19802 | 865.19335 | 4.67 | 125.0216 (100), 161.02182 (35), 245.04515 (31), 287.05295 (97), 289.06618 (86), 407.07193 (74), 425.08571 (57), 451.10024 (43), 575.11398 (40), 577.13152 (69), 695.13769 (46), 713.14353 (32), 865.19369 (35) | - | 235.53 | 406.64 |
| 7.54 | B type procyanidin trimer is. III e | C45H37O18− | 865.19802 | 865.19362 | 4.40 | 125.02128 (92), 161.01983 (27), 245.04142 (27), 287.04982 (100), 289.06626 (74), 407.07179 (69), 413.08225 (28), 425.07936 (50), 451.09678 (34), 577.12663 (52), 695.13371 (36), 713.14206 (23), 865.18764 (28) | - | 202.19 | 374.13 |
| ∑ | 132.15 | 1092.13 | 1755.29 | ||||||
| Flavonol derivatives | |||||||||
| 8.02 | Quercetin 3-O-(6″-O-rhamnosyl)-hexoside f | C27H29O16− | 609.14611 | 609.14524 | 0.86 | 150.99976 (5), 178.99516 (3), 271.0187 (8), 300.02243 (100), 301.02915 (77) | <LOQ | <LOQ | <LOQ |
| ∑∑ | 955.26 | 6063.61 | 8169.47 | ||||||
| No | RT | Compound Name | Formula | Calculated Mass | m/z Exact Mass | mDa | MS Fragments (%) | CBC (0%GS) | CB1 (2.5%GS) | CB2 (5.0%GS) |
|---|---|---|---|---|---|---|---|---|---|---|
| (Iso)-α-acids | % (% of lose) | |||||||||
| 1 | 12.05 | Hulupinic acid | C15H19O4− | 263.12830 | 263.12433 | 3.97 | 123.00615 (12), 125.99276 (100), 126.99623 (7), 137.99271 (7), 139.00046 (10), 151.00134 (37), 165.05173 (6), 179.03146 (8), 193.04723 (15) | 100 | 109.7 (-) | 80.9 (19.1) |
| 2 | 13.48 | Derivative of desoxy-tetrahydro-n/ad-humulone | C18H33O4− | 313.23790 | 313.23473 | 3.17 | 127.07332 (11), 129.08882 (47), 183.13532 (100), 184.1387 (14), 195.13506 (6), 277.21219 (6), 295.22312 (6), 313.23347 (3) | 100 | 52.7 (47.3) | 62.2 (37.8) |
| 3 | 12.46 | Cohulupone | C19H25O4− | 317.17530 | 317.17184 | 3.46 | 111.04264 (41), 133.06318 (42), 152.04504 (100), 153.04856 (11), 180.03998 (33), 193.04771 (8), 205.06588 (88), 206.07051 (14), 219.09951 (11), 220.10703 (36), 233.07867 (60), 234.08222 (10), 248.1022 (18) | 100 | 73.7 (26.3) | 65.4 (34.6) |
| 4 | 10.92 | Desdimethyl-octahydro-iso-cohumulone | C18H33O5− | 329.23280 | 329.22901 | 3.79 | 125.09433 (5), 127.11033 (13), 139.10989 (18), 171.09981 (42), 183.13602 (22), 193.11996 (8), 211.13085 (100), 212.13389 (17), 229.14098 (32), 230.14422 (5) | 100 | 104.6 (-) | 106.0 (-) |
| 5 | 13.00 | Desoxy-iso-cohumulone⁄or hulupone-like | C20H27O4− | 331.19090 | 331.18728 | 3.62 | 125.05836 (34), 166.0606 (100), 167.05951 (13), 191.06802 (49), 194.05577 (32), 205.05262 (16), 219.07866 (80), 220.08251 (13), 234.123 (32), 247.09469 (59), 262.11782 (21) | 100 | 66.4 (33.6) | 55.9 (44.1) |
| 6 | 14.41 | Iso-Hulupone | C20H27O4− | 331.19148 | 331.18754 | 3.95 | 123.00519 (47), 125.05746 (87), 164.08067 (24), 165.05239 (52), 166.05965 (100), 167.06488 (20), 191.06706 (75), 192.07463 (62), 221.11397 (19), 235.12962 (72) | 100 | 58.5 (41.5) | 35.5 (64.5) |
| 7 | 11.59 | Iso- (n/ad)-posthumulone is. I | C19H25O5− | 333.17020 | 333.16705 | 3.15 | 111.04256 (52), 167.06726 (10), 168.03977 (15), 169.04714 (21), 181.04757 (8), 209.11404 (4), 221.07836 (13), 237.10996 (100), 238.11351 (18) | 100 | 33.9 (66.1) | 19.8 (80.2) |
| 8 | 13.21 | Iso- (n/ad)-posthumulone is. II | C19H25O5− | 333.17020 | 333.17041 | −0.21 | 111.0061 (7), 125.05815 (11), 151.03733 (18), 163.07332 (25), 167.0319 (100), 168.0391 (62), 195.02632 (44), 219.09929 (37), 220.10455 (11), 223.09406 (7), 237.10959 (10) | 100 | 68.5 (31.5) | 55.2 (44.8) |
| 9 | 8.56 | Desdimethyl-n/ad-humulinone | C19H23O6− | 347.14950 | 347.14899 | 0.51 | 111.04198 (47), 125.0568 (10), 193.08256 (19), 231.06157 (14), 235.09467 (14), 259.09426 (6), 285.14461 (9), 305.1337 (8), 329.13289 (6), 347.14537 (100), 348.14809 (27) | 100 | 128.0 (-) | 91.9 (8.1) |
| 10 | 16.84 | Cohumulone | C20H27O5− | 347.18580 | 347.18265 | 3.15 | 165.05258 (10), 166.0595 (4), 193.04719 (18), 207.06296 (53), 223.05777 (16), 235.0586 (100), 236.06274 (19), 278.11254 (80), 279.11606 (17) | 100 | 65.7 (34.3) | 69.9 (30.1) |
| 11 | 14.89 | Iso-cohumulone | C20H27O5− | 347.18580 | 347.18310 | 2.70 | 111.04208 (31), 125.05762 (15), 165.05263 (16), 181.04694 (100), 182.05414 (87), 207.13539 (17), 209.04151 (53), 233.11433 (45), 234.1198 (14), 251.12487 (13) | 100 | 101.6 (-) | 92.1 (7.9) |
| 12 | 15.37 | Iso- (n/ad)-humulone is. I | C21H29O5− | 361.20150 | 361.19834 | 3.16 | 125.05838 (47), 167.06825 (11), 179.06852 (23), 195.06315 (92), 196.07057 (100), 197.07418 (13), 221.15171 (20), 223.0579 (58), 235.13084 (10), 247.13086 (42), 248.13594 (13), 265.14134 (14) | 100 | 75.0 (25.0) | 43.2 (56.8) |
| 13 | 15.57 | Iso- (n/ad)-humulone is. II | C21H29O5− | 361.20150 | 361.19905 | 2.45 | 125.05768 (46), 163.07306 (27), 167.06757 (11), 179.06772 (22), 195.06235 (100), 196.06967 (93), 221.15068 (18), 223.05695 (54), 247.13007 (47), 251.12469 (11), 259.12231 (10), 265.14019 (16) | 100 | 103.8 (-) | 93.2 (6.8) |
| 14 | 16.11 | Iso- (n/ad)-humulone is. III | C21H29O5− | 361.20150 | 361.19836 | 3.14 | 125.0582 (33), 163.07365 (19), 179.06825 (17), 195.06328 (100), 196.07059 (95), 221.15165 (17), 223.05838 (49), 247.13104 (44), 251.1256 (11), 265.14128 (15) | 100 | 62.5 (37.5) | 52.1 (47.9) |
| 15 | 13.54 | Dihydro-cohumulinone | C20H29O6− | 365.19640 | 365.19317 | 3.23 | 181.04691 (3), 195.06272 (8), 209.07799 (11), 223.058 (26), 237.07351 (50), 238.07798 (9), 296.12313 (100), 297.12638 (23) | 100 | 90.8 (9.2) | 93.8 (6.2) |
| 16 | 11.32 | (Iso)- (n/ad)-Prehumulone | C21H27O6− | 375.18080 | 375.17985 | 0.95 | 125.05814 (17), 139.07366 (43), 191.07187 (7), 211.05809 (7), 220.07157 (7), 223.13034 (14), 239.05301 (8), 263.12551 (100), 264.12887 (15), 291.12044 (4) | 100 | 59.8 (40.2) | 43.5 (56.5) |
| 17 | 11.45 | (n/ad)-humulinone is. I | C21H29O6− | 377.19640 | 377.19187 | 4.53 | 125.05807 (19), 139.07367 (47), 179.06844 (5), 192.07635 (7), 211.0581 (8), 220.07185 (9), 223.13093 (12), 239.05299 (9), 263.12553 (100), 264.12922 (22), 291.12029 (4) | 100 | 75.6 (24.4) | 66.4 (33.6) |
| 18 | 11.86 | (n/ad)-humulinone is. II | C21H29O6− | 377.19640 | 377.19279 | 3.61 | 125.05817 (22), 139.07356 (25), 179.06802 (7), 195.06312 (15), 207.10217 (8), 211.0582 (7), 220.07235 (6), 223.1303 (15), 239.05285 (8), 263.12559 (100), 264.12824 (19), 283.15112 (6) | 100 | 76.5 (23.5) | 66.0 (34.0) |
| 19 | 12.67 | (n/ad)-humulinone is. III | C21H29O6− | 377.19640 | 377.19287 | 3.53 | 125.0584 (21), 139.07372 (100), 141.05346 (14), 165.05261 (7), 179.06831 (7), 181.12033 (6), 223.1311 (20), 263.12545 (39), 264.12903 (7) | 100 | 88.9 (11.1) | 78.4 (21.6) |
| 20 | 11.92 | Dihydro-n/ad-humulinone | C21H31O6− | 379.21210 | 379.20740 | 4.70 | 125.05746 (52), 127.0729 (29), 155.06825 (25), 179.06809 (33), 195.06172 (39), 207.09827 (89), 210.04955 (16), 237.10824 (27), 251.12092 (17), 265.13808 (100), 266.14463 (32), 283.14996 (54), 310.13721 (16), 321.16509 (26) | 100 | 75.6 (24.4) | 66.7 (33.3) |
| Prenylflavonoids | ||||||||||
| 21 | 14.01 | Desmethylxanthohumol or 8-prenylnaringenin or 6-prenylnaringenin | C20H19O5− | 339.12320 | 339.12051 | 2.69 | 119.04678 (100), 120.05055 (10), 133.06233 (34), 151.07291 (15), 175.07185 (14), 219.06188 (50), 220.06562 (8), 245.07799 (3) | 100 | 32.5 (67.5) | 25.0 (75.0) |
Disclaimer/Publisher’s Note: The statements, opinions and data contained in all publications are solely those of the individual author(s) and contributor(s) and not of MDPI and/or the editor(s). MDPI and/or the editor(s) disclaim responsibility for any injury to people or property resulting from any ideas, methods, instructions or products referred to in the content. |
© 2024 by the authors. Licensee MDPI, Basel, Switzerland. This article is an open access article distributed under the terms and conditions of the Creative Commons Attribution (CC BY) license (https://creativecommons.org/licenses/by/4.0/).
Share and Cite
Milinčić, D.D.; Salević Jelić, A.S.; Lević, S.M.; Stanisavljević, N.S.; Milošević, T.; Pavlović, V.B.; Gašić, U.M.; Obradović, N.S.; Nedović, V.A.; Pešić, M.B. Craft Beer Produced by Immobilized Yeast Cells with the Addition of Grape Pomace Seed Powder: Physico-Chemical Characterization and Antioxidant Properties. Foods 2024, 13, 2801. https://doi.org/10.3390/foods13172801
Milinčić DD, Salević Jelić AS, Lević SM, Stanisavljević NS, Milošević T, Pavlović VB, Gašić UM, Obradović NS, Nedović VA, Pešić MB. Craft Beer Produced by Immobilized Yeast Cells with the Addition of Grape Pomace Seed Powder: Physico-Chemical Characterization and Antioxidant Properties. Foods. 2024; 13(17):2801. https://doi.org/10.3390/foods13172801
Chicago/Turabian StyleMilinčić, Danijel D., Ana S. Salević Jelić, Steva M. Lević, Nemanja S. Stanisavljević, Teodor Milošević, Vladimir B. Pavlović, Uroš M. Gašić, Nataša S. Obradović, Viktor A. Nedović, and Mirjana B. Pešić. 2024. "Craft Beer Produced by Immobilized Yeast Cells with the Addition of Grape Pomace Seed Powder: Physico-Chemical Characterization and Antioxidant Properties" Foods 13, no. 17: 2801. https://doi.org/10.3390/foods13172801
APA StyleMilinčić, D. D., Salević Jelić, A. S., Lević, S. M., Stanisavljević, N. S., Milošević, T., Pavlović, V. B., Gašić, U. M., Obradović, N. S., Nedović, V. A., & Pešić, M. B. (2024). Craft Beer Produced by Immobilized Yeast Cells with the Addition of Grape Pomace Seed Powder: Physico-Chemical Characterization and Antioxidant Properties. Foods, 13(17), 2801. https://doi.org/10.3390/foods13172801

